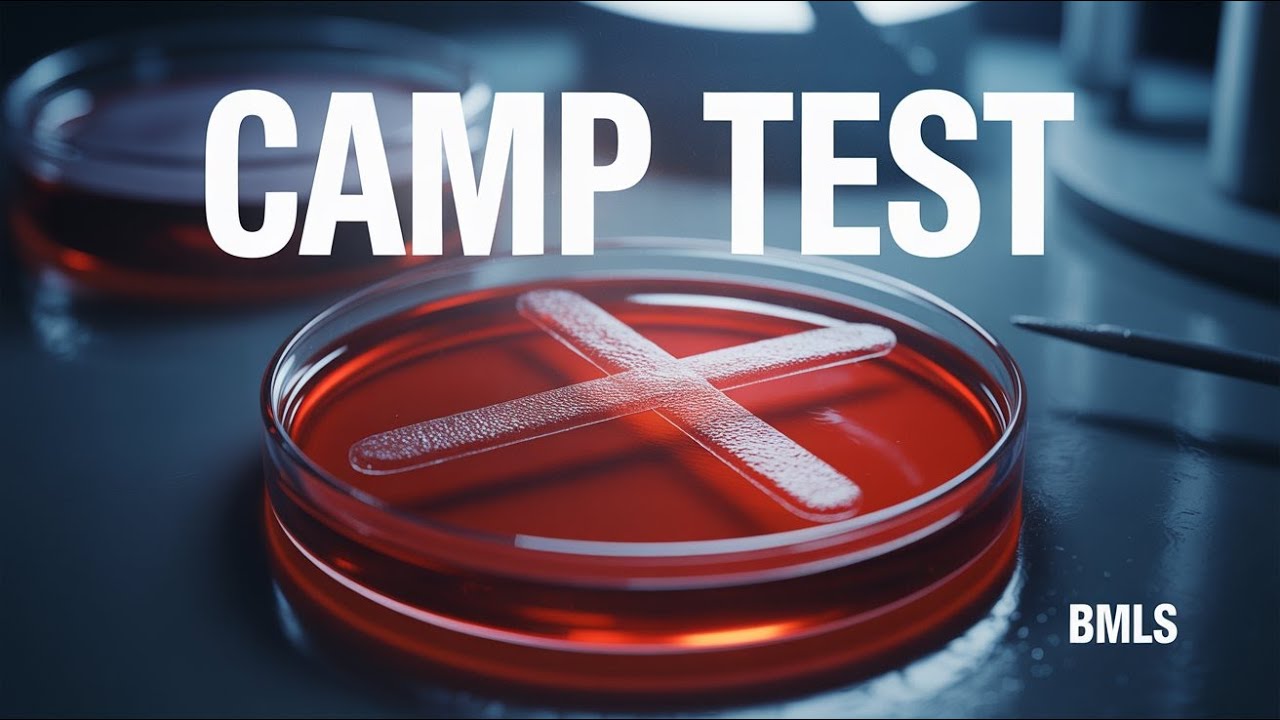
CAMP Test | Principle, Procedure & Result Interpretation | Systematic Bacteriology | BMLS

May–Hegglin Anomaly | Hematological Diseases | Giant Platelets & Döhle-Like Bodies | BMLS
Автор: Shrii!!!!BMLS Pathshala
Загружено: 2026-02-07
Просмотров: 59
Описание:
🩸 May–Hegglin Anomaly | Hematological Diseases | Giant Platelets & Döhle-Like Bodies | BMLS
👩⚕️👨⚕️ BMLS Students – Important Rare Hematological Disorder!
In this video, we explain May–Hegglin Anomaly (MHA), a rare inherited platelet disorder characterized by giant platelets, thrombocytopenia, and Döhle-like inclusion bodies in neutrophils. This topic is highly important for hematology theory, practicals & viva.
🔬 What is May–Hegglin Anomaly?
🔹 A rare autosomal dominant hematological disorder
🔹 Belongs to MYH9-related disorders
🔹 Affects platelets and neutrophils
🧬 Etiology / Cause:
📌 Mutation in MYH9 gene
📌 Abnormal myosin heavy chain
📌 Leads to defective platelet formation
🩸 Key Features of May–Hegglin Anomaly:
✔ Giant platelets 🟣
✔ Thrombocytopenia (↓ platelet count)
✔ Döhle-like bodies in neutrophils 🔵
✔ Usually normal bleeding time
✔ Often asymptomatic or mild bleeding
🔍 Peripheral Blood Smear Findings:
🧫 Platelets → Large / giant platelets
🧫 Neutrophils → Pale blue Döhle-like inclusions
🧫 RBCs → Usually normal
📊 Laboratory Findings:
📌 Decreased platelet count
📌 Normal platelet function tests
📌 Normal PT & APTT
📌 Peripheral smear is diagnostic ⭐
⚠️ Clinical Features:
🔹 Often asymptomatic
🔹 Mild bleeding tendency
🔹 Easy bruising
🔹 Epistaxis (rare)
Follow us for more updates:
Telegram Channel :-
link :- https://t.me/shrii1119
🚀 Join the fun on Instagram! Follow us for updates, insights, and more! link :- https://www.instagram.com/shrii_1119?...
📚 Ideal For:
VIDEO LECTURE :-
Medical Law & Ethics | BMLS 1st Semester
Link :- • Medical Law & Ethics | BMLS 1st Semester
Human Anatomy & Physiology | BMLS 2nd Semester
Link :- • Human Anatomy & Physiology | BMLS 2nd Seme...
Detailed lecture on Culture Media in Microbiology
link :- • Culture Media ( BMLS )
UNIT :-1 Introduction to Medical Microbiology
Link :- • UNIT :-1 Introduction to Medical Microbiology
Systematic Bacteriology | BMLS 3rd Semester
Link:- • Systematic Bacteriology | BMLS 3rd Semester
Basic of Hematological Diseases | BMLS 3rd Ssmester
Link :- • Basic of Hematological Diseases | BMLS 3rd...
PREVIOUS YEAR QUESTION PAPAER
PLAYLIST:- 01
BMLS 1st Semester main exam paper
Link :- • BMLS 1st Semester main exam paper
PLAYLIST:- 02
BMLS 2nd Semester main exam paper
Link :- • BMLS 2nd Semester main exam paper
PLAYLIST:- 03
BMLS 3rd Semester main exam paper
Link :- • BMLS 3rd Semester main exam paper
PLAYLIST:- 04
BMLS 4th Semester main exam paper
Link :- • BMLS 4th Semester main exam paper
PLAYLIST :-05
BMLS 5th Semester main exam paper
Link :- • BMLS 5th Semester main exam paper
PLAYLIST :-06
BMLS 5th Semester main exam paper
Link :- • BMLS 6TH Semester main exam papers.
PLAYLIST :-07
BMLS 7th Semester main exam paper
Link :- • BMLS 7th Semester main exam paper
📌 Devices I use for recording & editing videos:
🎥 Camera/Phone: https://amzn.to/3ITyVOJ
🎤 Microphone:https://amzn.to/3KK5IpJ
💻 Laptop: https://amzn.to/4nfzoIS
💡 Ring Light/Setup: https://amzn.to/4hsrE5e
🖥️ Editing Software: https://www.adobe.com/in
🧠 Differential Diagnosis:
❌ Immune thrombocytopenic purpura (ITP)
❌ Bernard–Soulier syndrome
❌ Other giant platelet disorders
🎯 Why is May–Hegglin Anomaly Important?
✔ Asked in Hematological diseases – BMLS
✔ Important peripheral smear diagnosis
✔ Frequently confused with ITP in exams
✔ Viva favorite topic 🔥
👥 Who Should Watch This Video?
👩🔬 BMLS Students
👨🔬 BMLT / DMLT Students
🎓 Allied Health Science Students
🩺 Hematology Learners
🔔 Support the Channel
👍 Like | 💬 Comment | 📤 Share | 🔔 Subscribe
for more Hematology & Exam-Oriented Medical Lab Content
🔎 SEO Keywords / Tags:
May Hegglin anomaly
Giant platelet disorder
MYH9 related disorders
Döhle like bodies neutrophils
Hematological diseases BMLS
🏷 Hashtags:
#MayHegglinAnomaly 🩸
#HematologicalDiseases
#GiantPlatelets
#DohleBodies
#BMLS
Повторяем попытку...

Доступные форматы для скачивания:
Скачать видео
-
Информация по загрузке: